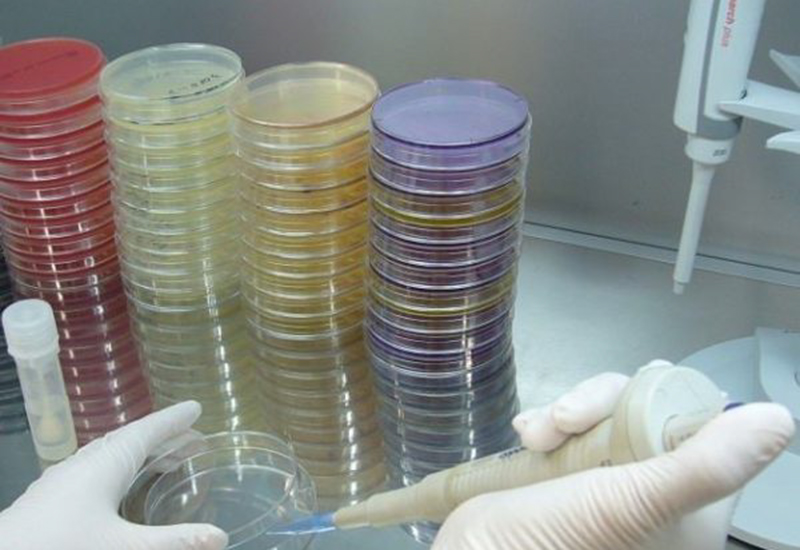

ご依頼の流れ・検査依頼書ダウンロード
検査をご検討・ご依頼いただきまして、誠にありがとうございます。
検査の流れを大まかにご説明します。各種依頼書もダウンロードできますのでご利用ください。
ご不明な点がございましたら、お気軽にお問い合わせください。
ご相談・ご依頼
検査項目についてご相談いただくことも多くございます。弊社には環境分析のノウハウがありますので、弊社担当者が検査シーンごとに検査項目のアドバイスを行うことが可能です。お気軽にご相談ください。
メールフォームからもお問い合わせ可能です→メールフォーム
検査内容、納期、サンプリングなど弊社担当との打合せ後、ご依頼いただきます(依頼書、電話、メールにてご依頼をお受けいたします)。依頼書は以下からダウンロードできます。
※環境未来WEB(通販サイト)の腸内細菌検査依頼書はこちらから
サンプリング(採取・搬送)
弊社より検査キット、依頼書、手順書をお送りいたします。お客様に採取・採水していただく場合と弊社担当者が採取・採水に伺う場合がございます。また飲料水など検体・検査目的によっては、弊社担当者が採水・運搬させていただきます。
■検体持ち込みの場合、以下住所までお持込下さい。
営業時間:平日 8:30 ~ 17:30
(土曜でも受付可能な場合がございます。事前にご相談ください)
〒390-1242 長野県松本市和田4010-5
TEL:0263-88-3911 FAX:0263-88-3366


分析・検査
定められた方法(公定法など法令、条例、その他指針等に基づく検査方法)で検査・分析を行います。

検査結果書の発行・お渡し
公的に有効な報告書等(計量証明書、衛生検査結果書など)が発行されます。電子納品、郵送により報告書を納品いたします。
お急ぎの場合は事前に担当営業までご相談ください。(検査項目によっては対応をいたしかねる場合もございますので予めご了承ください)。
